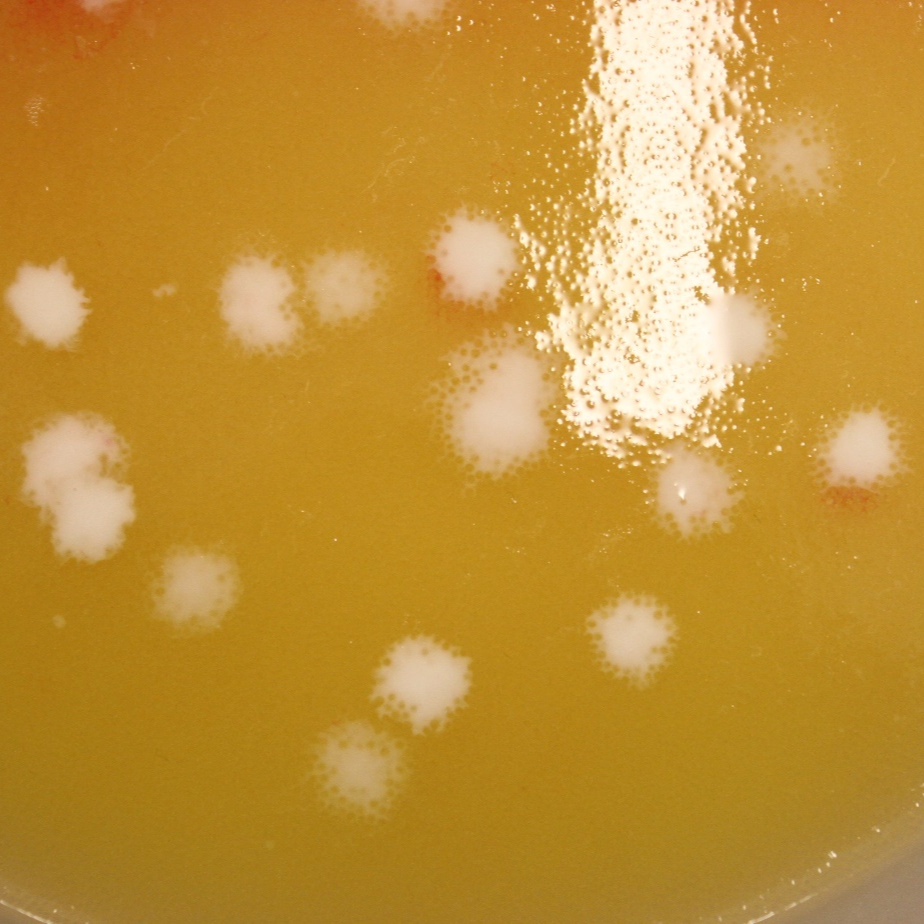

виды рыб являются объектами разведения.
Статус селекционно-племенного хозяйства позволяет воспроизводить широкий спектр ценных и редких видов пресноводной рыбы, в том числе краснокнижных.
Мы выращиваем молодь ценных видов рыбы как для разведения и продажи, так и для зарыбления водоёмов Украины с целью восстановления экологического равновесия и возвращения эндемиков в историческую среду обитания.
Стабильность размерного ряда, четкий контроль качества и регулярность поставок позволяют планировать календарные объемы готовой продукции.

Зарыбковый материал
В результате сотрудничества с факультетом биоинженерии животных Варминско-Мазурского университета в Ольштыне (Польша) мы внедрили технологии искусственного воспроизводства и производства зарыбкового материала нескольких видов рыб для зарыбления открытых водоемов страны и для дальнейшего разведения в прудах или рециркуляционных аквакультурных системах (RAS). К ним относятся щука, судак, налим и карповые реофильные (речные) рыбы, такие как вязь и жерех. В ближайшем будущем мы готовимся к внедрению дальнейших технологий для различных видов рыб, включая занесенные в Красную книгу Украины, - елец, голавля, усача, карася, сига и осетровых.
Решения для рыбоводов
Биотехнологии, разработанные наукой, могут быть как закрытыми, то есть подлежащими патентной защите, так и открытыми, то есть изложенными в виде общедоступных научных публикаций. Однако даже в последнем случае рыбоводам трудно получить соответствующие решения, хотя бы из-за языкового барьера, поскольку лучшие научные журналы публикуются на английском языке и, кроме того, доступ к деталям некоторых публикаций является платным. Поэтому для того, чтобы технология нашла свое применение в сельскохозяйственной практике, необходимый трансфер знаний из науки.
Трансфер технологий
В странах бывшего "коммунистического блока" до сих пор не существует системных решений, которые бы способствовали такой прямой передачи. Аквакультура в Польше и Украине имеет схожие условия, хотя бы в силу географического положения, но в течение многих лет существовал барьер для передачи технологий из Польши в Украину. В настоящее время ситуация постепенно меняется. Это связано с индивидуальными действиями партнеров с польской и украинской сторон. Примером такого международного сотрудничества является трансфер из Польши и внедрение в Украине технологий в области интенсивной аквакультуры (разведение рыбы) и природоохранной аквакультуры (для зарыбления открытых водоемов), инициатором и катализатором которого является Международный Консалтинговый Центр «АгроТехЭксперт» и пан Ян Маньковский. В течение нескольких лет он принимал активное участие в налаживании контактов и сотрудничества между украинской и польской сторонами в области разведения и выращивания рыбы. Несколько лет деятельности Центра привели к тому, что он начал осуществлять конкретные действия.
Первые испытания по применению данной технологии в украинских условиях были проведены в 2019 году в хозяйстве ООО «Бестер Плюс» (г. Яворов, Львовская обл.). Оказалось, что эта технология работает, и интерес к зарыбковому материалу судака (осенние мальки, двухлетки) просто невероятный. В зависимости от потребностей разведение судака проводят в прудах или в инкубатории. Последний способ дает большие производственные возможности, и мы хотели бы его вам представить.
(https://onlinelibrary.wiley.com/doi/10.1111/j.1365-2109.2011.02879.x).
Уникальная система основаннная как на положении ядра в ооцитах, так и на коагуляции жировых шариков в ооцитах, позволила создать 7-балльную шкалу зрелости яиц судака. Эта система позволяет очень точно определить время овуляции у самки судака, что означает:
– Уменьшение манипуляций с нерестовиками, что непосредственно повышает выживаемость нерестовиков
– Повышение качества яиц, непосредственно влияющее на качество личинок, мальков и снижение каннибализма
– Значительное повышение экономической рентабельности производства и улучшение качества производимого зарыбочного материала
| Загрузить пособие |

(более 1 миллиона икринок внутри аппарата)
- Оплодотворенная икра
- Личинка
- Личинка подрощенная
- Малёк летний (для зарибления рек, озер, прудов)
- Зарыбок летний - приученный потреблять коммерческий корм (особенно подходит для разведения в RAS)
- Осенний зарыбок
Биотехнология воспроизводства налима в контролируемых условиях, позволяющая синхронизировать нерест и получать гаметы высокого качества, была разработана сотрудниками действующей кафедры ихтиологии и аквакультуры факультета биоинженерии животных Варминско-Мазурского университета в Ольштыне.
Прорывные результаты воспроизведения налима в контролируемых условиях, описанные в данной публикации, уже успешно применяются в промышленных инкубаториях многих стран, в том числе и нашей страны. Полученный таким методом племенной или зарыбковый материал является сильным и дает возможность поддерживать этот вид в естественных условиях или развивать его интенсивное разведение.
На фото: Проклёв налима после трёх недель выращивания в RAS
| Загрузить публикацию |
На фото: Налим во всей красе
- Оплодотворенная икра
- Личинка
- Личинка подрощенная
- Малёк летний (для зарыбления рек, озер, прудов)
Siberian sturgeon (Acipenser baeri Brandt). Aquaculture, 305, 174 – 177.

